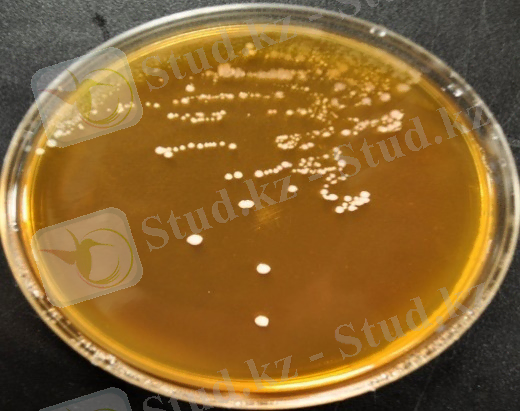
https://iridescentscribblings.files.wordpress.com/2012/06/pediococcus.jpg

Шикі ысталған шұжықтарды өндіруде бастапқы бактериялық дақылдардың технологиялық қолданылуы және өнім сапасын арттыру


Шұжық өндіру технологиясында ет шикізаттарын өңдеуге арналған микроорганизмдердің бастапқы дақылдарын қолдану
КІРІСПЕ
Шикі ысталған шұжықтардың тиімді технологиясын құрудың перспективалы бағыты бастапқы дақылдарды қолдана отырып, ет жүйесінің компоненттерін түрлендірудің биохимиялық, физика-технологиялық және микробиологиялық үдерістеріне бірлесіп әсер ету арқылы олардың сапасын қалыптастыру үдерістерін мақсатты реттеу болып табылады.
Әлемнің түрлі елдерінің ғалымдары іргелі және қолданбалы зерттеулері арқылы тамақ өнімдерінің функционалдық қасиеттерін айқындайтын ингредиенттер арасында асқазан-ішек жолының қалыпты микрофлорасын қалыптастыратын пробиотикалық қасиеттерге ие микроорганизмдердің ерекше орын алатындығын айқын дәлелдеген. Бұл пробиотикалық қасиеттері бар тағамның маңыздылығын қалыптастырудың шешуші факторларының бірі болып келеді.
Микроорганизмдердің пробиотикалық қасиеттері тұрғысынан пропион қышқылы және бифидобактериялар үлкен қызығушылық тудыруда, олар қоршаған ортаеың мутагендеріне қарсы көп деңгейлі қорғаныстық қасиетке ие.
Осыған байланысты жоғары технологиялық потенциалы бар және антимутагендік қасиеттері бар пробиотикалық микроорганизмдерді шикі ысталған шұжықтарды өндіруде бастапқы дақыл ретінде қолдану өзекті де және перспективалы болып табылады.
Электромагниттік импульспен белсендірілген бактериялық бастапқы дақылдарды қолдана отырып, шикі ысталған шұжықтарды өндіру технологиясын қолдану үрдісті тездету үшін оңтайлы болып келеді. Осы технологияны пайдалану арқылы оның биохимиялық қасиеттері мен микробиологиялық көрсеткіштері бойынша шикізатқа қойылатын талаптарды төмендетеді. Еттің бастапқы рН-ын реттеуге мүмкіндік туындайды. Етті жаңа піскен, ұсталған, піскен немесе мұздатылған күйінде пайдалануға болады. Белсендірілген бактериялық дақылдарды қолданудың жағымды жағы-олардың белсенділігі, бұл белгілі бір өндіріс жағдайларында әртүрлі биохимиялық бастапқы параметрлері бар ет өнімдерін алуға мүмкіндік береді.
Ет ақуыздарының изоэлектрлік нүктесіне жақын аралықтағы рН мәні (5, 1-5, 5) су байланыстыру қабілетін төмендетуге жақсы жағдай жасап қана қоймайды және сәйкесінше кептіру үшін шикі шұжықтарды бояуға жауап беретін нитрозопигменттерді қалыптастыру үшін де оңтайлы болып табылады.
1 Технологиялық бөлім
1. 1 Шикі ысталған шұжықтардың тиімді технологиясын құрудың перспективалы бағыттары
Жұмыстың өзектілігі. Тамақтанудың тиімділігі - адам популяциясының денсаулығын анықтайтын негізгі факторлардың бірі. Денсаулық сақтау саласындағы мемлекеттік саясат, атап айтқанда дұрыс тамақтану, адам тамағы рационының жоғары сапалы және қауіпсіз тамақ өнімдерін әзірлеумен белсенді айналысады.
Жетекші орындарды біздің отанымыздың тұрғындарының рационында жануарлардан алынатын өнімдер, соның ішінде шұжық өнімдері алып отыр. Шұжық өнімдерін тұтынудың жоғары деңгейі байқалады, көп жағдайда сатып алушылар шикі ысталған шұжықтарға кқңіл бөлетіні анықталып отыр. Шикі ысталған шұжықтар, өз кезегінде, ең тығыз консистенцияға, жағымды ерекше дәм мен хош иіске ие. Шикізат ресурстарын пайдалану тиімділігін арттыру және шығарылатын өнімнің ассортименттерін жетілдіру - шикі ысталған шұжықтарды дайындау көлемін ұлғайтудың, сондай-ақ дайын өнімнің ассортименттерін жаңғыртудың қажетті шарттары болып табылады.
Шикілей ысталған шұжықтар тұтынушылар арасында үлкен сұранысқа ие, дәмдік сапасы жоғары. Алайда, шикілей ысталған шұжықтарды өндіру өте ұзақ және қымбат болып келеді. Ет өнімдерінің осы түрін өндіруді жеделдету және оған шығындарды азайту мақсатында бастапқы дақылдарды қолданады. Ферментация жылдамдығын арттыруға және шикі ысталған шұжықтардың кептіру уақытын азайтуға мүмкіндік беретін көптеген технологиялық әдістер бары белгілі. Осы әдістердің бірі - ет шикізатын өңдеу үшін микроорганизмдердің бастапқы дақылдарын қолдану болып келеді.
Қазіргі әлемде әртүрлі шикі ысталған шұжықтардың өндірісі бір орында тұрмайтыны белгілі. Дайын өнімнің сапасын жақсарту үшін ферментацияның жаңа әдістері жиі пайда болуда. Бастапқы дақылдар бұл дайын өнімнің шығымдылығына, оның мөлшеріне, сапасына және түсінің қарқындылығына әсер ететін ең көп таралған әдістердің бірі[1] .
Ет өнімдерін өндіруде бастапқы дақылдарды қолдану іс жүзінде кең таралған және қымбат шикі ысталған шұжықтарды өндіруде кеңінен қолданылады. Оларды қолдану натрий нитритінің ыдырауын, түсінің түзілуін реттеуге, шикі ысталған өнімдердің ерекше хош иісін жасауға, микрофлораның жағымсыз өсуін тоқтатуға, шикізаттың сусыздану үдерістеріне әсер етуге мүмкіндік береді. Сөзсіз, натрий нитриті улы зат екенін атап өткен жөн. Натрий нитритінің өзі канцероген болмаса да, белгілі бір жағдайларда термиялық өңдеу кезінде немесе ағзада N-нитрозоаминдер - күшті канцерогенді заттар пайда болуы мүмкін деген теория бар екені белгілі. Натрий нитритінің қайта қалпына келуі және оны қайта қалпына келгенімен әрекеттесетін өнімдерінің миоглобинмен әрекеттесуі ортаның белсенді қышқылдығына байланысты, ал реакциялар рН төмен болған жағдайда толық және қарқынды жүреді. Оның түсінің түзілу реакциялары үшін оңтайлы мәні 5, 0-6, 0 аймағында орналасқан. Шикі ысталған шұжықта болатын химиялық өзгерістер секілдімаңызды нәрсені елемеуге болмайды. Бастапқы дақылдарды кесудің алғашқы кезеңдерінде енгізген кезде рН қысқа мерзімде қажетті мәндерге дейін төмендетуге болады. рН тез төмендеуі рН 7, 0-7, 4 диапазонында оңтайлы дамуы алатын шірік микрофлораның өсуін тежеу үшін ғана емес, сонымен қатар кептіру жылдамдығына да айтарлықтай әсер етеді. Ет ақуыздарының изоэлектрлік нүктесіне жақын аралықтағы рН мәні (5, 1-5, 3) және электромагниттік өріспен өңделген шикізат су байланыстыру қабілетін төмендетуге және сәйкесінше кептіруге жақсы жағдай жасайды, шикі шұжықтарды бояуға жауап беретін нитрозопигменттерді қалыптастыру үшін оңтайлы болып табылады.
Технологиялық сипаттамаларға келетін болсақ, қазіргі уақытта бастапқы дақылдардың дайын өнімнің шығуына, оның санына, сапасына және түс қарқындылығының дәрежесіне әсері ететіні анықталды.
Дайын өнімнің физикалық өзгерістері жартылай фабрикаттарды өндіруге жарамды еттің: 15-17% -дан 40-43% -ға дейін шығуында көрінеді. Еттің пісу үдерісі бірнеше есе артады. Тез жетілетін бастапқы дақылдарды кең таралған және сұранысқа ие ететін айқын артықшылығы - шикі ысталған шұжықтарды 18-21 күн ішінде өндірудің қысқа мерзімі болып табылады. Баяу жетілетін бастапқы дақылдары бар өндіріске 5-7 күнге көп уақыт кетеді. Алайда, шұжықтардың тез жетілуіне арналған бастапқы дақылдардың кемшіліктеріне дайын өнімде қышқыл дәмнің пайда болуы, сондай-ақ ыстаудың кешігуі немесе жеткіліксіз қарқындылығы кезінде қабығының көгеруін жатқызуға болады. Бірақ мұның бәрін бастапқы дақылдарды дұрыс пайдалану және рецепттің барлық тармақтарын сақтау арқылы болдырмауға болады .
Бастапқы дақылдар - шикі ысталған шұжықтардың сапасын қалыптастырудың маңызды факторы болып табылады. Бастапқы дақылдардың әртүрлі түрлерін қолдану осы ет өнімдерін өндірудің сапасы мен технологиясын тікелей анықтайды. Ұйытқыдағы дұрыс таңдалған дақылдар өнімнің жағымды дәмі мен хош иісін қалыптастыруға, түстерін тұрақтандыруға ғана емес, сонымен қатар шіріткіш және санитарлық бактериялардың тіршілігін басуға, дайын өнімнің шығымдылығын арттыруға ықпал ететіндігі айқын[2] .
1. 2 Шұжық өнімдерін өндіру үшін бастапқы дақылдарды пайдаланудың қазіргі жай-күйі мен перспективалары
1. 2. 1 Бастапқы дақылдар шұжық сапасын қалыптастырудың факторы ретінде
Перспективалы бағыттардың бірі ет өнімдерін өндіру үшін микроорганизмдердің өмірлік маңызды өнімдеріне негізделген биологиялық белсенді заттарды жасау және пайдалану деп танылуы қажет.
Ұйытқылармен бірге енгізілген микроорганизмдер ферменттер арқылы шұжықтардың құрылымын өзгерте отырып, өнімнің сапасын жақсартуға ықпал ететін жаңа заттар түзетіндігі анықталған.
Көптеген микроорганизмдердің белсенділігі олардың негізгі қасиеттеріне байланысты: өзгеріп отыратын өмір сүру жағдайларына тез бейімделуі, тез көбею қабілеті және мүмкін биохимиялық реакциялардың кең спектріне байланысты болып келеді.
Бастапқы дақылдар ретінде негізінен нитратты төмендететін микрококтар, гомоферментативті сүтқышқылды бактериялары мен педиококктар, ашытқылар және таза немесе аралас дақылдар түрінде әдеттегі емес сүтқышқылды бактериялары қолданылады. [3]
Әдеби көздерден ет өнімдерін тұздау кезінде микрофлора кем дегенде технологиялық тұрғыдан маңызды үш құбылыста: бояуды тұрақтандыруда, ет өнімдерінің органолептикалық сипаттамаларын жақсартуда және сақтауды арттыруда белсенді рөл атқаратыны белгілі.
Микрофлораның құрамы шикізатқа, тұздау шарттары мен режиміне байланысты болып келеді. Уақыт өте келе, тұздықта бактериялардың жалпы санындағы сүт қышқылдылардың, ал сүтқышқылдылардың арасында тұздау жағдайларына бейімделген штаммдардың саны, атап айтқанда және Streptococcuslactis үлесі артады.
Алайда, тіпті тұздау жағдайларына бейімделген бұл штамдар жаңа тұздықтарда дамымайды және алғашқы алты күн ішінде тек спирттік ашыту сипатымен лаг-фазадан ғана өтеді. Тек ашытудан кейін ғана сүтқышқылына жақындайды. Осыдан тәжірибеде салыстырмалы түрде тұрақтандырылған микрофлорасы бар ескі тұздықтарды қолданудың орындылығы дұрыс екендігіне көз жеткізуге болады. Арнайы дайындалған бастапқы дақылдарды немесе комбинацияларды қолдану одан да перспективалы болып табылады[4] .
1. 2. 2 Бастапқы бактериялық дақылдардың әртүрлі түрлерін қолдану
Бастапқы бактериялық дақылдардың әртүрлі түрлерін қолдану шикі ысталған шұжықтар мен шикі ысталған тұтас бұлшықет өнімдерін өндірудің сапасы мен технологиясын тікелей анықтайды.
Микроорганизмдердің көмірсуларының алмасуы нәтижесінде хош иістің пайда болуында өте маңызды рөл атқаратын өнімдер пайда болады. Сүтқышқылымен қатар пирожүзімді, сірке қышқылы, этил спирті, ацетоин және басқа да заттар шикізатқа, содан кейін ет өнімдеріне ұзақ уақыт сақталатын дәм мен хош иіс береді.
Сүтқышқылды бактериялар тек тұрақсыз метаболизмге ие және өзгермелі бейімделу арқылы алмасуының арқасында қоршаған ортаның өзгеруіне бейімделе алады. Шұжыққа арналған тартылған етіке бактериялық ұйытқылар түрінде енгізілгенде, олардың метаболизмінің өнімдері хош иісті қалыптастыруда маңызды рөл атқарады. Микроорганизмдер және олардың ферментативті кешендері еттің негізгі компоненттерін жоюды және оларды дайын өнімнің органолептикалық қасиеттерін, оның адам ағзасындағы сіңімділігін, биологиялық құндылығы мен тұтынушы үшін қауіпсіздігін анықтайтын дәмдік, хош иісті және физиологиялық белсенді қосылыстарға айналдыруды жүзеге асырады.
Ет өнімдерінің консистенциясы, басқа факторлармен қатар, бұлшықет ақуыздарының (саркоплазмалық және миофибриллярлы) әсеріне байланысты болып келеді. Ет өнімінде протеолиз неғұрлым күшті болған сайын, соғұрлым нәзік бола түсді. Бактериялық дақылдар протеолитикалық белсенділігіне байланысты және рН төмендеуі арқылы консистенцияға әсер етеді: бұл екі әрекет бактериялардың метаболизмінің салдары болып табылады. Еттің рН саркоплазмалық ақуыздардың изоэлектрлік нүктесіне тең мәндерге дейін төмендеген кезде, соңғысы тұндырылып, су шығарады, бұл өнімнің жақсы консистенциясын қалыптастыруға ықпал етеді. Микроорганизмдермен инокуляцияланған кезде рН төмендеуі жылдамырақ жүреді, бұл да тиісті консистенцияның тез дамуына алып келеді[5] .
Бірқатар ет өнімдерін өндіру үрдісінде рН бақылау көптеген себептерге байланысты қажет болып табылады. Шұжық етінің қатаю үрдістері үшін рН-ның төмен мәні өте маңызды. Дәл 5, 2-5, 3-ке жақын рН төмен мәндерінде коллагеннің ісінуі, молекулааралық байланыстардың гидролизі және жасуша ферменттерінің, әсіресе катепсиндердің белсендірілуі жүреді, олар үшін оңтайлы рН мәні 3, 8-4, 5 құрайды. Сонымен қатар, тартылған еттің рН 5, 2-5, 4 мәндеріне тез және үздіксіз төмендеуі ондағы патогендік және токсикогендік бактериялардың дамуын тежейді.
Сонымен, зерттеулер Clostridiumbotulinum өсуін тежеу үшін шұжық етіне қосылған нитриттердің деңгейін сүтқышқылды бактерияларын енгізу арқылы азайтуға болатындығын анықтады. Сонымен қатар, бактериялық дақылдар Salmonella, Clostridium Botulinum, Staphilococcusaureus секілді микроорганизмдерге қатысты ет өнімдерінде антагонистік әсер көрсетеді.
Микробиологиялық үрдістің маңызды жанама өнімі фермент каталаза -антиоксидант болып табылады, ол бөлме температурасында ұзақ уақыт сақтау кезінде ет өнімдерінің бүлінуіне жол бермейді. Дайын өнімге каталазаны енгізу мүмкін емес, ал тартылған етке дайындау кезеңінде қосу ыстау кезінде оның инактивациясының жоғары ықтималдығына байланысты өте қиын болып табылады.
Демек, ет өнімдерінің құрылымында микрофлораның қызметі нәтижесінде біркелкі бөлінген каталазаның пайда болуы бактериялық препараттарды қоспалар ретінде қолданудың оң салдары болып келеді[6] .
Оң технологиялық қасиеттері бар микроорганизмдерді қолданумен қатар, адам ағзасындағы сау биоценозды анықтайтын бактериялық препараттардың құрамына штамдарды енгізу мүмкіндігін зерттеу өте маңызды болып келеді. Соңғысы асқазан-ішек жолындағы ашыту үрдістерін, қоректік заттардың сіңу деңгейін ынталандырады. Бүгінгі таңда адамның қалыпты микрофлорасының өкілдерін қолдана отырып, бактериялық препараттарды жасау ең перспективалы болып табылады.
Lactobacillus plantarum (сур. 1) стрептобактерияларға жатады және әлсіз қышқыл түзуші болып табылады. Өсудің оңтайлы температурасы-30°C. Стрептобактериялар 15°C-та өсуімен және 45°C-та болмайды немесе өте әлсіз өсуімен сипатталады.


Сурет 1- Lactobacillus plantarum
Lactobacillus fermenti(сур. 2) -бета бактериялар тобының гомоферментативті сүтқышқылды таяқшалары. Бұлар өте әлсіз қышқыл түзгіштер, олардың қасиеттері хош иісті сүтқышқылды стрептококктарының қасиеттеріне жақын болып келеді.


Сурет 2- Lactobacillus fermenti
Ет өнеркәсібінде Pediococcus cerevisiae (сур. 3) - кеңінен қолданылады, алғашқы екі штаммы ұйытқы ретінде, екінші екеуі хош иісті түзуші зат ретінде. Pediococcus cerevisiae алғаш рет 1957 жылы коммерциялық бакпрепарат ретінде қолданыла бастады. Шикі ысталған және шикі қақталған шұжықтарды өндіру кезінде рН төмендеуі олардың пісу үрдісін едәуір жылдамдатуға мүмкіндік береді.
Pediococcus cerevisiae штаммы ет өнеркәсібінде ұйытқы және хош иісті түзуші зат ретінде қолданылады. Оның көмегімен рН мөлшерін көмірсулар қоспасын, сонымен қатар коагуляция ұзақтығын және ұшпа қышқылдардың мөлшерін мөлшерлеу арқылы реттеуге болады.

Сурет 3- Pediococcus cerevisiae штамм
Ет өнімдерін өндірудегі жетекші микрофлораны зерттеу кезінде зерттеушілер зерттелген шикі ысталған, шикі қақталғаг шұжық, ысталған сан еті, тұздықтардың микрофлорасы негізінен сүтқышқылды бактерияларымен ұсынылатындығын анықтады. Дайын өнімде сүт қышқылы бактерияларының басым болуы оларға шикі шұжықтар мен тұзды ет өнімдерін ферментациялауда маңызды рөл атқаруға негіз береді. Осыған байланысты психофильді сүтқышқылды микроорганизмдерін бөліп алу үшін келесі іздеу жүргізіле бастады. Осылайша, сүтқышқылының типсіз бактериялары анықталды: Lactobacillus casei (Lactobacillus casei) және Lactobacillus curvatus, оны әдеттегі лактобактериялармен бірге қолдану пісіп-жетілу үрдісін тездетіп, ферменттелген ет өнімдерінің сапасын арттырды. Сүтқышқылды микроорганизмдерінің осы түрлеріне тән белгілер каталаза мен нитрит редуктазасының болуымен сипатталады. Екі фермент - гемтәуелсіз және гемтәуелді екі формамен ұсынылған. Мысалы, гемтәуелді нитритредуктаза нитритті азот тотығына дейін бөледі, бұл ет шикізатының түсіне жағымды әсер етеді. Алайда, бұл ферменттердің кездесуі тән емес және де ұқсас белсенділікті әдетте осы микроорганизмдердің «жабайы» штамдарында байқалады. Осы екі штаммның шартты-патогенді микрофлораға және бүліну қоздырғыштарына қатысты жоғары антагонистік белсенділігі атап өтілді[7] .
Сүтқышқылды таяқшалары: Lactobacillus acidophilus, Lactobacillus bulgaricus өнеркәсіптік маңызы зор болып келеді. Олар көптеген сүт өнімдерін және жартылай құрғақ ысталған шұжықтарды өндіруде қолданылады. Олардың қышқыл мен тұзға төзімділігі, әртүрлі температурада, ауа болған кезде және болмаған кезігде даму қабілеті сүтқышқылды таяқшаларының таралуына ықпал етеді. Бұл микроорганизмдер белсенді қышқыл түзушілер болып табылады. Lactobacillus acidophilus және Lactobacillus bulgaricum дақылдары сүтқышқылының ашытуының гомоферментативті түрімен сипатталады. Сүтқышқылды таяқшаларының жоғары ацидофильділігі, рН 3, 0-3, 5, бактериялардың жасушаларына рибофлавиннің көп мөлшерде жиналуына байланысты, бұл өз кезегінде жасушаның тыныс алу үрдістеріне ықпал етеді.
Lactobacillus acidophilus және Lactobacillus bulgaricum протеолитикалық белсенділікке ие болып келеді. Казеин гидролизінің дәрежесі бойынша сүтқышқылды таяқшалары азаю жағына қарай қатарға тұрады: Lactobacillus bulgaricum, Lactobacillus acidophilus, Lactobacillus helveticum, Lactobacillus lactis, Lactobacillus casei, Lactobacillus plantanun және т. б. сүтқышқылды стрептококктарынан айырмашылығы, сүтқышқылды таяқшалары айқын ферментативті протеолитикалық жүйеге ие, дамыған пептидазалар мен протеиназалар кешені бар. Нәтижесінде олар казеиннің 25-30%-ын еритін формаға айналдыра алады.
Бұл микроорганизмдердің дамуының температуралық оптимумындағы алшақтық бөлінген штаммға сүтқышқылды микроорганизмдерін белсендіргенге дейін натрий нитритін тиімді төмендетуге мүмкіндік береді, бұл сүтқышқылды микроорганизмдерінің Paracoccussp штаммына қатысты ғана емес, айқын антагонизмге ие болуына байланысты, сонымен қатар рН төмендету арқылы денитрификация үдерісіне қатысты маңызды болып келеді. Бұл жағдайда азот оксиді шикізатта жиналады, ол рН одан әрі төмендету жағдайында түс түзілу реакциясы үшін ең қолайлы жағдайларды қамтамасыз етім береді[8] .
1. 2. 3 Ет шикізаты мен материалдарының сипаттамасы
Шұжық өнімдері пісірілген (шұжықтар, шұжықша, қысқа шұжықтар), Пісіріліп-ысталған, жартылай ысталған және шикідей ысталған, және де шикідей қақталған болып бөлінеді.
Шұжықтар еттен және союдың басқа да өнімдерінен де жасауға болады. Шұжық өнімдерін өндіру үшін сау жануарлардан алынатын шикізат пайдаланылады.
Ет шикізатының ішінде сиыр еті мен шошқа еті ең көп үлесін алады. Кейбір аймақтарда қой, ешкі, жылқы, буйвол, қодас, бұғы, жабайы аңдар мен құс етін қолданады.
Ет бумен пісірілген (тек қайнатылған шұжықтар, шұжықша мен қысқа шұжықтар жасау үшін), суыған, салқындатылған, мұздатылған немесе еріген күйінде қолданылады. Ет шұжық цехтарына сүйектерімен қаңқа, жартылай ұша, кесілген түрінде немесе сүйексіз мұздатылған блоктар түрінде келіп түседі.
Ет сау жануарлардан жақсы болуы қажет және оны ветеринариялық-санитариялық қызметі тамақ үшін жарамды деп тануы қажет. Кейбір жағдайларда ветеринарлық қадағалаушының рұқсатымен, егер одан әрі технологиялық өңдеу оны толығымен залалсыздандыруды қамтамасыз етсе, ауру жануарларынан алынған шартты түрде жарамды етті пайдалануға да болады. Құс еті (тауық, күркетауық, үйрек, қаз) және қоян еті шикі ысталған және шикі қақталған шұжықтардан басқа, шұжық өнімдерінің барлық түрлерін өндіру үшін қолданылады. Ұшалары жақсы өңделуі қажет, ішектері жоқ, мұқият жуылуы қажет.
Ластануларды, ұрылғандарын, ұюған қандарын, ендерін алып тастау қажет. Иісі жоқ ұшалар терең, бірақ беткі қабаты жылтырап көгерген және ұрылғандарынан тазартып, ыстық (50°С) және суық сумен жуылып тазаланады. Ерітілген ет, әдетте, сумен жуылады. Мәжбүрлі союдың еті мен қосалқы өнімдері және шартты түрде жарамды еті тек кейін және ветеринарлық қадағалаудың рұқсатымен ғана жіберіледі.
Шпик ақ түсті, қалыпты иісі бар, ластанбаған болуы қажет. Дәмдеуіштер мен дәмтатымдылықтары өзіне тән ерекше хош иісі мен дәмі болуы және құрамында бөгде қоспалардың болмауы тиіс.
Ішек қабығы стандарттың талаптарын қанағаттандыруы қажет. Жасанды қабықтарда техникалық шарттарға сәйкес беріктігі мен өлшемдері де тексеріледі[9] .
Шұжықтарды тоқу үшін қолданылатын бау стандарттың талаптарына сәйкес келетіндігін тексеру қажет.
Пісірілген шұжықтарды өндіруде сиыр еті мен шошқа етін буланған, салқындатылған және ерітілген түрдегі күйде; басқа түрдегі шұжықтарды өндіру үшін - салқындатылған және ерітілген күйде ғана қолданады.
Жоғары сұрыпты ысталған және жартылай ысталған шұжықтарды екі рет мұздатылған еттен жасауға болмайды. Шикі ысталған шұжықтарды өндіру үшін тек жоғары сұрыпты шикізатты пайдаланады, тартылған етке су қосылмайды, тартылған етті қабыққа өте тығыз етіліп құйылады. Ұзақ (5 - 7 тәулік) тұнбадан кейін шұжық пісіру үрдісін айналып өтіп, суықпен ыстайды (18- 22 °C, 5-7 күн), содан кейін барып ұзақ кептірілуден (25-30 күн, 10-12 °C) өтеді. Бүкіл үрдіс шамамен 50 күнге созылады. Қазіргі таңда шикі ысталған шұжықтарды өндіру үрдісін жеделдету үшін ферменттік препараттарды қолданады. Оларды қолданудың арқасында технологиялық үрдіс екі есе қысқаруда.
... жалғасы- Іс жүргізу
- Автоматтандыру, Техника
- Алғашқы әскери дайындық
- Астрономия
- Ауыл шаруашылығы
- Банк ісі
- Бизнесті бағалау
- Биология
- Бухгалтерлік іс
- Валеология
- Ветеринария
- География
- Геология, Геофизика, Геодезия
- Дін
- Ет, сүт, шарап өнімдері
- Жалпы тарих
- Жер кадастрі, Жылжымайтын мүлік
- Журналистика
- Информатика
- Кеден ісі
- Маркетинг
- Математика, Геометрия
- Медицина
- Мемлекеттік басқару
- Менеджмент
- Мұнай, Газ
- Мұрағат ісі
- Мәдениеттану
- ОБЖ (Основы безопасности жизнедеятельности)
- Педагогика
- Полиграфия
- Психология
- Салық
- Саясаттану
- Сақтандыру
- Сертификаттау, стандарттау
- Социология, Демография
- Спорт
- Статистика
- Тілтану, Филология
- Тарихи тұлғалар
- Тау-кен ісі
- Транспорт
- Туризм
- Физика
- Философия
- Халықаралық қатынастар
- Химия
- Экология, Қоршаған ортаны қорғау
- Экономика
- Экономикалық география
- Электротехника
- Қазақстан тарихы
- Қаржы
- Құрылыс
- Құқық, Криминалистика
- Әдебиет
- Өнер, музыка
- Өнеркәсіп, Өндіріс
Қазақ тілінде жазылған рефераттар, курстық жұмыстар, дипломдық жұмыстар бойынша біздің қор #1 болып табылады.



Ақпарат
Қосымша
Email: info@stud.kz